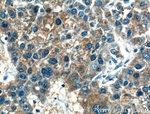
Gamma cystathionase Antibody in Immunohistochemistry (Paraffin) (IHC (P))

Search
Proteintech
Gamma cystathionase Monoclonal Antibody (2C7F9)
{{$productOrderCtrl.translations['antibody.pdp.commerceCard.promotion.promotions']}}
{{$productOrderCtrl.translations['antibody.pdp.commerceCard.promotion.viewpromo']}}
{{$productOrderCtrl.translations['antibody.pdp.commerceCard.promotion.promocode']}}: {{promo.promoCode}} {{promo.promoTitle}} {{promo.promoDescription}}. {{$productOrderCtrl.translations['antibody.pdp.commerceCard.promotion.learnmore']}}
产品信息
60234-1-IG
种属反应
已发表种属
宿主/亚型
分类
类型
克隆号
抗原
偶联物
形式
浓度
规格
纯化类型
保存液
内含物
保存条件
运输条件
产品详细信息
Immunogen sequence: AVAALDGAK YCLAFASGLA ATVTITHLLK AGDQIICMDD VYGGTNRYFR QVASEFGLKI SFVDCSKIKL LEAAITPETK LVWIETPTNP TQKVIDIEGC AHIVHKHGDI ILVVDNTFMS PYFQRPLALG ADISMYSATK YMNGHSDVVM GLVSVNCESL HNRLRFLQNS LGAVPSPIDC YLCNRGLKTL HVRMEKHFKN GMAVAQFLES NPWVEKVIYP GLPSHPQHEL VKRQCTGCTG MVTFYIKGTL QHAEIFLKNL KLFTLAESLG GFESLAELPA IMTHASVLKN DRDVLGISDT LIRLSVGLED EEDLLEDLDQ ALKAAHPPSG SHS (74-406 aa encoded by BC015807)
靶标信息
This gene encodes a cytoplasmic enzyme in the trans-sulfuration pathway that converts cystathione derived from methionine into cysteine. Glutathione synthesis in the liver is dependent upon the availability of cysteine. Mutations in this gene cause cystathioninuria. Alternative splicing of this gene results in two transcript variants encoding different isoforms.
仅用于科研。不用于诊断过程。未经明确授权不得转售。
生物信息学
蛋白别名: CGL; CTL target antigen; cystathionase (cystathionine gamma-lyase); Cystathionine gamma-lyase; Cysteine desulfhydrase; Cysteine-protein sulfhydrase; Gamma-cystathionase; Homocysteine desulfhydrase; homoserine deaminase; homoserine dehydratase; MGC9471; PRB-RA; Probasin-related antigen; unnamed protein product
基因别名: 0610010I13Rik; AI314617; BC019483; CGL; CSE; CTH; Cys3; H
UniProt ID: (Human) B4E1R2, (Rat) P18757, (Mouse) Q8VCN5
Entrez Gene ID: (Human) 1491, (Rat) 24962, (Mouse) 107869